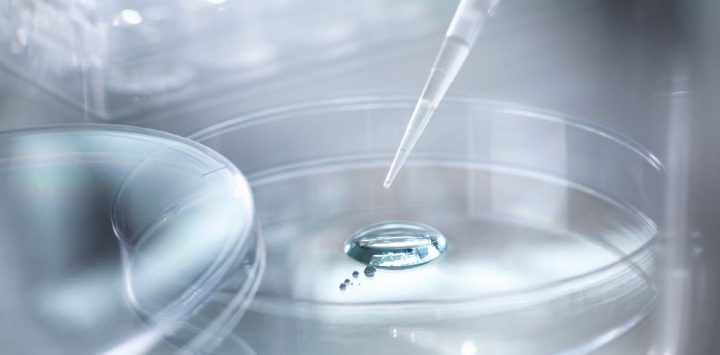

Case導入事例
-

月30時間の業務削減と属人化の解消を実現した有隣堂の資金管理DX
株式会社有隣堂 -

承認作業“10分の1”に短縮。監査指摘の解消と属人化からの脱却を実現― 医学・看護教育と4附属病院を支える慈恵大学が着手した経理DX ―
学校法人慈恵大学 -

25口座の一元管理と順番待ちゼロを実現─日本生活協同組合連合会が語る BizHawkEye導入のリアル
日本生活協同組合連合会 -

月額コスト1/10&毎朝40分の作業が数分に!シチズン時計がBizHawkEyeで実現した経理DXと働き方改革
シチズン時計株式会社 -

年間280時間の業務削減と800枚のペーパーレス化を実現!BizHawkEye導入で経理DXと働き方改革を推進
株式会社NITTAN -

年間240時間の業務削減を実現!BizHawkEye導入で経理効率と内部統制を強化
日清物流株式会社 -

前田建設工業の経理改革が「大成功」したワケ、カギとなる「バンキングシステム」とは
前田建設工業株式会社 -

BizHawkEyeで業務効率化とコスト削減を両立月間15時間の短縮、年間40%のシステム費用削減を実現!
株式会社エーテック -

すかいらーくが「経理DX」と「脱ISDN回線」を同時にかなえた、ここだけの秘訣とは
株式会社すかいらーくホールディングス -

フロッピーディスクを月200枚使用…岩国市の“時代遅れ”業務を大転換した「経理DX」
岩国市役所 -

小田急不動産の経理がバンキングシステムで一新した理由、「DX推進」の軌跡とは?
小田急不動産株式会社 -
一石四鳥で大成功「タカラバイオのDX戦略」、毎日1時間の時短を叶えた“脱ISDN”とは
タカラバイオ株式会社 -

工数は“10分の1”に、日本自動車ターミナルが経理業務を「劇的改善」できたワケ
日本自動車ターミナル株式会社 -

東洋アルミニウムが「前時代的」資金管理業務を改革したら、どんな効果があった?
東洋アルミニウム株式会社 -

インターネットバンキングだと難しい複数取引先の管理、一発解決した方法とは
株式会社東京カンテイ -

アクトグループが約20の口座情報を一元管理し、業務時間を「1/3」に短縮した方法
アクトグループ株式会社